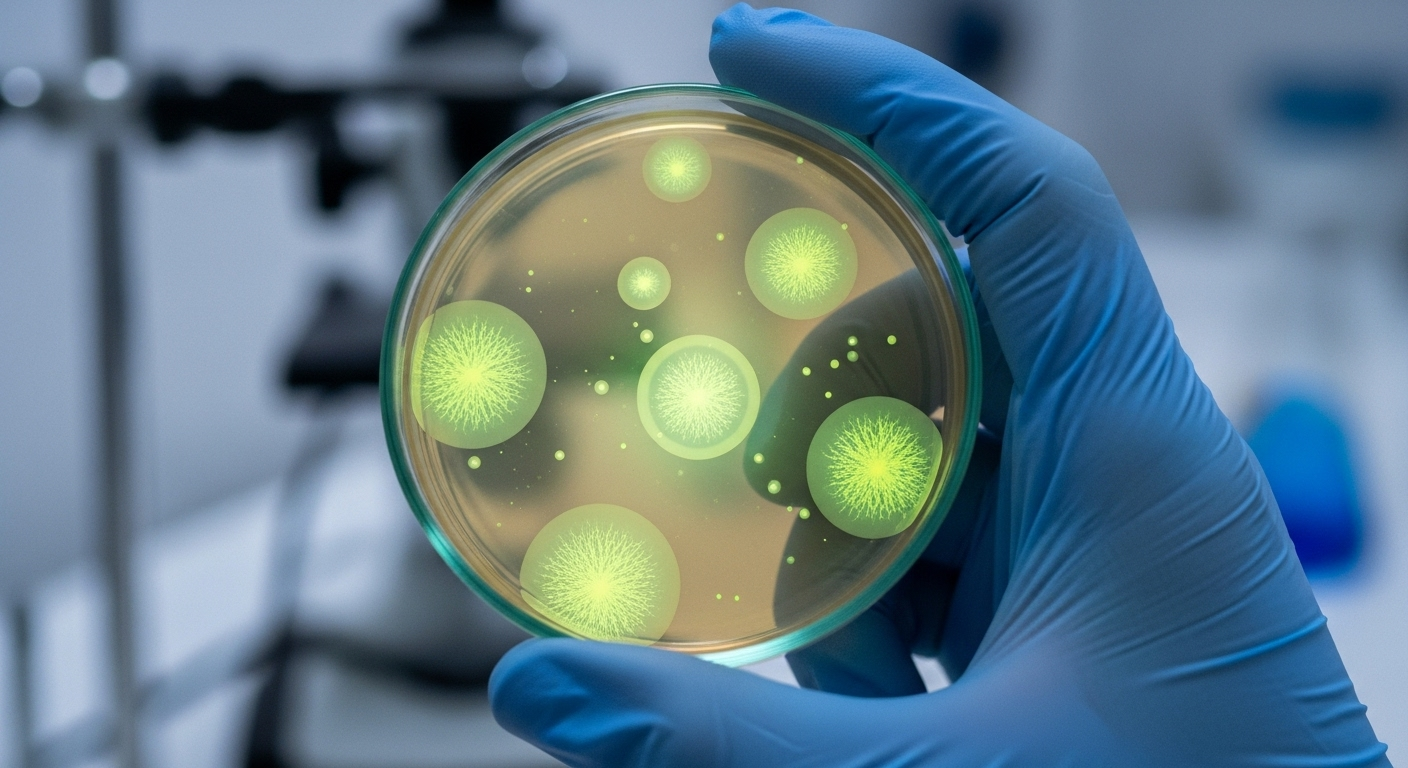
La solution ? une levure transformée en usine à stérols

Un nouveau “superaliment” pourrait sauver à la fois les abeilles et la planète
Auteur: Mathieu Gagnon
On le sait tous, les abeilles sont essentielles. Elles sont un peu les factrices de la nature, transportant le pollen de fleur en fleur. Sans elles, pas de fruits, pas de légumes, ou en tout cas beaucoup moins. Une grande partie de ce que nous mangeons chaque jour dépend de leur travail acharné.
Mais voilà, nos petites travailleuses sont en difficulté. Le monde change trop vite pour elles. Imaginez un peu : des champs immenses avec une seule et unique culture à butiner sur des kilomètres, et un climat qui chamboule tout le calendrier des fleurs. Forcément, les abeilles se retrouvent parfois le ventre vide. C’est un vrai problème, qui peut décimer des ruches entières.
Le problème du garde-manger vide

Quand la nourriture naturelle vient à manquer, les apiculteurs leur donnent des substituts pour les aider à tenir le coup. C’est un peu comme si nous mangions des barres énergétiques en attendant un vrai repas. Ça maintient les abeilles adultes en vie, oui, mais ça ne suffit pas pour la nouvelle génération. Les larves, les bébés abeilles, ne s’y développent pas bien du tout.
Une étude récente a enfin mis le doigt sur le pourquoi du comment. Et, bonne nouvelle, elle propose une solution concrète qui pourrait tout changer.
Le secret est dans les graisses : les fameux stérols

Alors, qu’est-ce qui manquait dans leur gamelle ? Des graisses très spéciales appelées stérols. Pour faire simple, c’est un peu comme le cholestérol pour nous. C’est indispensable pour construire les cellules du corps et pour fabriquer les hormones qui guident la croissance. Un peu le ciment et le chef de chantier du corps de l’abeille.
Le truc, c’est que les abeilles ne peuvent pas fabriquer ces stérols elles-mêmes. Elles doivent absolument les trouver dans le pollen. Et pas n’importe lesquels ! Des chercheurs ont regardé de très près ce dont les larves avaient besoin et ils ont trouvé la recette exacte. L’ingrédient principal, qui compose les deux tiers du mélange, s’appelle le 24-méthylènecholestérol. Il est accompagné de cinq autres compères en plus petites quantités.
Une bouchée sur trois, ça compte !

Pour bien comprendre l’importance de tout ça, il faut savoir qu’environ une bouchée de notre nourriture sur trois dépend directement du travail des abeilles. Danielle Downey, qui dirige une association dédiée à leur santé (Project Apis m.), le confirme : une bonne nutrition est la clé pour rendre les colonies plus fortes face à tous les dangers qui les menacent.
Elle explique que cette découverte a un potentiel immense. En ajoutant ces fameux stérols à la nourriture des abeilles, on pourrait grandement améliorer la survie des ruches. Et donc, par la même occasion, aider les apiculteurs et sécuriser la production de notre nourriture. C’est exactement ce que les professionnels observent : quand le pollen manque, les adultes survivent, mais les naissances s’arrêtent. Maintenant, on sait pourquoi.
La solution ? une levure transformée en usine à stérols
Le hic, c’est que le stérol principal, le fameux 24-méthylènecholestérol, est très rare dans la nature et quasi impossible à produire en grande quantité. Alors comment faire ?
Les scientifiques ont eu une idée brillante. Ils se sont tournés vers une petite championne du monde de la production de graisses : une levure (la même famille que la levure de bière ou de boulanger). Grâce à des techniques de pointe, ils ont, en quelque sorte, « reprogrammé » cette levure. Ils lui ont appris à fabriquer pile la bonne recette des six stérols nécessaires aux abeilles.
Au lieu de s’embêter à extraire ces stérols un par un, ils ont tout simplement mélangé cette levure spéciale, pleine de bonnes graisses, directement dans la nourriture des abeilles. Malin, non ?
Le test final : un succès pour les futures générations d'abeilles

Le moment de vérité, c’était bien sûr de tester cette nouvelle nourriture. Les résultats ont été sans appel. Les ruches qui ont reçu une nourriture complète mais SANS les bons stérols ont vu leurs naissances chuter rapidement.
En revanche, les colonies nourries avec le mélange contenant la levure spéciale ont continué à élever leurs petits pendant bien plus longtemps. C’est une victoire énorme, car cela permet aux ruches de rester fortes et peuplées même pendant les périodes difficiles, sans s’effondrer.
Comme le dit le professeur Geraldine Wright, qui a dirigé l’étude, c’est une preuve qu’on peut utiliser la science pour résoudre des problèmes écologiques bien réels. On a enfin un moyen de donner aux abeilles ce qui leur manque quand la nature ne peut pas le faire.
Conclusion : Ce n'est pas une solution miracle, mais un immense pas en avant

Attention, cette nourriture ne va pas tout régler comme par magie. Les abeilles font toujours face à d’autres menaces comme les pesticides ou les parasites. Rien ne remplacera jamais de belles prairies fleuries et diversifiées. C’est une évidence.
Mais, c’est un outil formidable et un grand pas dans la bonne direction. On sait maintenant précisément ce qui manque aux abeilles et on a une solution pour le leur fournir. Bien sûr, il faudra encore vérifier que c’est abordable, que ça se conserve bien, etc. Mais c’est une lueur d’espoir. En aidant les abeilles de ruche, on pourrait même réduire la compétition pour la nourriture avec les abeilles sauvages, qui en ont bien besoin aussi.
Finalement, ce « super-aliment » à base de levure ne remplacera jamais une fleur, mais il pourrait bien devenir le meilleur ami des apiculteurs lorsque le garde-manger de la nature est un peu vide.
Selon la source : earth.com










